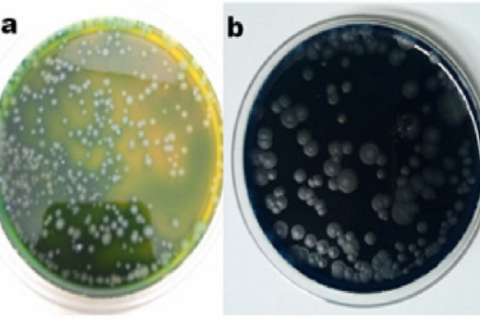
Carr agar medium (a) After acetic acid production (b) After over oxidation

Asian Journal of Biological and Life sciences, Vol 9, Issue 2, May-Aug, 2020
Recent Articles
Research Article
Diversity and Abundance of Earthworms in Different Landuse Patterns: Relation with Soil Properties
Sharanpreet Singh,Jaswinder Singh,Adarsh Pal Vig
Asian J. Biol. Life Sci.,9(2):111-118 DOI: 10.5530/ajbls.2020.9.18 Published: Wed, 3-Feb-2021 Read More
Research Article
Extraction of Keratin from Human Hair with Production of Biofertilizer from Waste Liquid of Hair Extraction and its Efficient Application on Growth Yield of Abelmoschus esculentus L
Gayathri Unnikrishnan,Vijayaraghavan Ramasamy
Asian J. Biol. Life Sci.,9(2):119-128 DOI: 10.5530/ajbls.2020.9.19 Published: Wed, 3-Feb-2021 Read More
Research Article
Categorizing Functional Yoghurt using Artificial Neural Network
JK Pallavi,M Sukumar
Asian J. Biol. Life Sci.,9(2):129-138 DOI: 10.5530/ajbls.2020.9.20 Published: Wed, 3-Feb-2021 Read More
Research Article
Bio-functionalized Gold Nanoparticles: A Potent Probe for Profound Antibacterial Efficiency through Drug Delivery System
Manoj Singh,Subramanian Manikandan,Mukesh Yadav,Sunil Kumar,Nirmala Sehrawat,Vikas Meashi, ,Pranjal Sharma,Anil Kumar Sharma
Asian J. Biol. Life Sci.,9(2):139-144 DOI: 10.5530/ajbls.2020.9.21 Published: Wed, 3-Feb-2021 Read More
Research Article
Larvicidal Property of the Acidified Chitosan from Marine Crab Shell Wastes against Aedes aegypti
Rosalle Moreno Perez,Rosar Jane Toton Endaya,Fharnieza Sabdula Mohammad,Melbert Cabañog Sepe
Asian J. Biol. Life Sci.,9(2):145-151 DOI: 10.5530/ajbls.2020.9.22 Published: Wed, 3-Feb-2021 Read More
Research Article
Evaluation of Antioxidant and Antidiabetic Potential of Crude Protein Extract of Pumpkin Seeds (Cucurbita maxima L.)
Sarah Jane Monica,Sheila John,Saraswathi K,Madhanagopal R,Arumugam P
Asian J. Biol. Life Sci.,9(2):152-157 DOI: 10.5530/ajbls.2020.9.23 Published: Wed, 3-Feb-2021 Read More
Research Article
Extraction and Molecular Characterization of Antimicrobial Metabolites from Streptomyces rochei against Bacterial Leaf Blight of Cotton Caused by Pantoea sp
Priti Patel,Gayatri Patel,Priya Mehta
Asian J. Biol. Life Sci.,9(2):158-162 DOI: 10.5530/ajbls.2020.9.24 Published: Wed, 3-Feb-2021 Read More
Research Article
Assessment of Enzymatic Potential of Soil Fungi to Improve Soil Quality and Fertility
Raj Singh,Sushil Kumar Upadhyay,Indu Sharma,Pooja Kamboj,Anju Rani,Permod Kumar
Asian J. Biol. Life Sci.,9(2):163-168 DOI: 10.5530/ajbls.2020.9.25 Published: Wed, 3-Feb-2021 Read More
Research Article
Effect of Free-Living Nitrogen Fixing and Phosphate Solubilizing Bacteria on Growth of Gossypium hirsutum L
Priti Patel,Khushbu Panchal
Asian J. Biol. Life Sci.,9(2):169-176 DOI: 10.5530/ajbls.2020.9.26 Published: Wed, 3-Feb-2021 Read More
Research Article
Selected Mollusks from Pujada Bay, Philippines: Heavy Metal Health Risk Assessment and Antibacterial Activities
Janeth Cuevas Tayone,Jeaneil Camille C. Ortiz,Wilanfranco C. Tayone
Asian J. Biol. Life Sci.,9(2):177-184 DOI: 10.5530/ajbls.2020.9.27 Published: Wed, 3-Feb-2021 Read More
Research Article
Zoonotic Transmission and Infection from Bovine Feces in Selected Ricefields of Lake Mainit, Philippines
Joycelyn C. Jumawan,Maria Karla M. Balamad,Leonardo A. Estaño
Asian J. Biol. Life Sci.,9(2):185-189 DOI: 10.5530/ajbls.2020.9.28 Published: Wed, 3-Feb-2021 Read More
Research Article
Phytoplankton Community Composition of Carigara Bay, Leyte and its Freshwater Tributaries
Hernando Alice Gera S,Susana F. Baldia,Paciente A. Cordero
Asian J. Biol. Life Sci.,9(2):190-199 DOI: 10.5530/ajbls.2020.9.29 Published: Wed, 3-Feb-2021 Read More
Research Article
Culture of Litopenaeus vannamei of Brackish Water in Summer Season with Artificial Diet
Ratna Sekar Puli,Ravi Babu Birudu,Danya Babu Ravuru, ,Jagadish Naik Mude
Asian J. Biol. Life Sci.,9(2):200-203 DOI: 10.5530/ajbls.2020.9.30 Published: Wed, 3-Feb-2021 Read More
Research Article
Microbiological Studies on Clostridium perfringens Isolated from Commercial Poultry of Balochistan
Ramla Achakzai,Muhammad Kamran Taj,Kamran Baseer Achakzai
Asian J. Biol. Life Sci.,9(2):204-208 DOI: 10.5530/ajbls.2020.9.31 Published: Wed, 3-Feb-2021 Read More
Research Article
Isolation and Identification of Thermotolerent Acetic Acid Bacteria from Waste Fruits
Bikash Kumar Sahoo,Rashmi Ranjan Mishra,Bikash Chandra Behera
Asian J. Biol. Life Sci.,9(2):209-213 DOI: 10.5530/ajbls.2020.9.32 Published: Wed, 3-Feb-2021 Read More
Research Article
Optimization of Statin Production from Aspergillus tamarii
Nidhiya Kizhakkoot Anilkumar,Arya Radhakrish Krishna,Jayaprabha Chockalingam,Lavanya Balakrishnan,Navitha Thanu Janarthanan,Praveen Ramachandran,Sharba Deepa Palanisami,Sharmila Srimathi Dhanaraj,Sindhya Joseph,Swathy Krishna Jayalekshmi,Trisha Mary Pandi Antony,Suganthi Ramasamy
Asian J. Biol. Life Sci.,9(2):214-219 DOI: 10.5530/ajbls.2020.9.33 Published: Wed, 3-Feb-2021 Read More
Research Article
Water Quality as a Priority Area of Community Needs Assessment: Community Extension Service with the Indigenous Tribe of Hanunuo Mangyan in the Philippines
vFrederick R. Masangkay,Giovanni D. Milanez,Luzelle Anne G.L. Ormita,Abel V. Alvarez,Myrna P. Quinto,Ferdianand F. Lanestosa,Lynda Christine Diaz,Paul Johnson,8Panagiotis Karanis Pa Karanis7
Asian J. Biol. Life Sci.,9(2):220-226 DOI: 10.5530/ajbls.2020.9.34 Published: Wed, 3-Feb-2021 Read More
Research Article
Effects of Plant Growth Regulators on in vitro Propagation of Economically Important Ornamental Plant Rosa hybrida L.
Diwakar Aggarwal,Sushil Kumar Upadhyay,Kuldeep Kumar,Nirmala Sehrawat,Hardeep Singh Tuli,Raj Singh
Asian J. Biol. Life Sci.,9(2):227-233 DOI: 10.5530/ajbls.2020.9.35 Published: Wed, 3-Feb-2021 Read More
Research Article
Micronutrient Foliar Spray on Growth Performance of Green Gram (Vigna radiata L.)
Smitanjali Nayak,Debabrata Nayak,Sagarika Parida
Asian J. Biol. Life Sci.,9(2):234-238 DOI: 10.5530/ajbls.2020.9.36 Published: Wed, 3-Feb-2021 Read More
Review Article
A Review on the Historical Development of Phytoplankton in the Philippines and their Biological Importance throughout the Years
Hernando Alice Gera S,Susana F. Baldia,Paciente A. Cordero
Asian J. Biol. Life Sci.,9(2):239-245 DOI: 10.5530/ajbls.2020.9.37 Published: Wed, 3-Feb-2021 Read More
Review Article
A Review Study on Efficacy of Immunomodulatory agents used for the Treatment of Covid-19
Abdulaziz Umar Kurya,Abdulhakim Umar Toro,Usman Rabiu Bello,Dinesh Chandra Sharma
Asian J. Biol. Life Sci.,9(2):246-250 DOI: 10.5530/ajbls.2020.9.38 Published: Wed, 3-Feb-2021 Read More
Review Article
Understanding Covid-19 Based on Clinical Insights and Recent Advancements in Therapeutic Discovery
Abdulaziz Umar Kurya,Usama Aliyu,Mu’azu Abubakar Gusau
Asian J. Biol. Life Sci.,9(2):251-259 DOI: 10.5530/ajbls.2020.9.39 Published: Wed, 3-Feb-2021 Read More
Short Communication